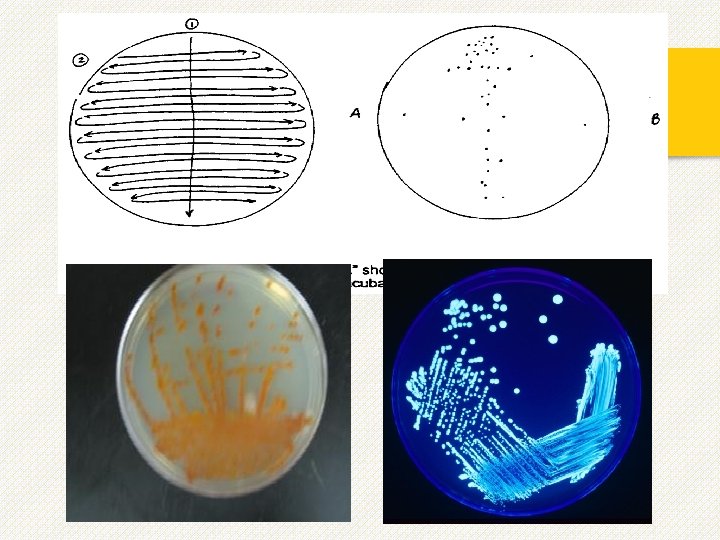

Media preparation and sterilization Aseptic technique pure culture

- Slides: 31
Media preparation and sterilization, Aseptic technique & pure culture concept Lab 7
Introduction v. In natural environments, microorganisms usually exist as mixed populations. However, if we are to study, characterize, and identify microorganisms, we must have the organisms in the form of a pure culture. v. A pure culture is one in which all organisms are descendants of the same organism. Techniques for obtaining pure cultures from a mixed population will be described in this Lab.
v In working with microorganisms, we must have a method of transferring growing organisms from a pure culture to a sterile medium without introducing any unwanted outside contaminants. This method of preventing unwanted microorganisms from gaining access is termed aseptic technique.
v. For the most part, bacterial physiology only can be studied in pure cultures. v. The best way to obtain a pure culture is to start with a single bacterial cell. v. This cell then divides quickly, and may produce millions of cells within 24 hours. v. A single unwanted contaminant cell can do the same thing in an otherwise pure culture, making the culture useless. For this reason, and to protect against disease, strict sterile procedures must be used.
Media preparation & sterilization v. In working with microorganisms we must also have a sterile nutrientcontaining-medium in which to grow the organisms. Anything in or on which we grow a microorganism is termed a medium. v Medium (media, plural): a nutrient blend used to support microbial growth. v. Re-hydrate powder according to manufacturer’s instructions. v. Micro-organisms are grown and sub-cultured on different types of chemical media; either chemically defined or synthetic or complex or non-synthetic.
v. A medium is sterilized (living organisms removed) before usage in the lab with different sterilization methods include: v. Autoclaving, Dry-heat, Filtration, UV exposure, Ethylene oxide.
v. Autoclave: The principle of sterilization in an autoclave is that steam under pressure is used to produce a temperature of 121ºC which if held for 15 minutes all microorganisms including bacterial endospores will be destroyed. v. Sterilization of equipment and materials § Wire loop: Heat to redness in Bunsen burner flame. § Empty glassware and glass (not plastic!) pipettes and Petri dishes: Either, hot air oven, wrapped in either grease proof paper or aluminum and held at 160 -180ºC for 2 hours, allowing additional time for items to come to temperature (and cool down!). üNote: plastic Petri dishes are supplied in already sterilized packs; packs of sterile plastic pipettes are also available but cost may be a consideration. § Culture media and solutions: Autoclave/pressure cooker. § Glass spreaders and metal forceps: Flaming in alcohol.
v. A sterile medium is one which is free of all life forms. It is usually sterilized by heating it to a temperature at which all contaminating microorganisms are destroyed. v. Colony: is the smallest bacterial unit that can be seen with the naked eye. v. Culture: Is part of specimen grown in cultural media. v. Culture media: is a medium(liquid or solid) that contains nutrients to grow bacteria in vitro. Because sometimes we cannot identify with microscopical examination directly, and sometimes we do culture for antibiotics sensitivity testing. v. Prosperities of Media: o. Media has to support the growth of bacteria, should be nutritive(contains the required amount of nutrients). o. With suitable p. H (neutral to slightly alkaline 7. 3 -7. 4). o. Suitable temperature. o. Suitable atmosphere (bacteria grow at 37 c).
Forms Of Culture Media 1) Broth tube: are tubes containing a liquid medium. A typical nutrient containing broth medium such as Trypticase Soy broth , nutrient broth. After incubation, growth (development of many cells from a few cells) may be observed as one or a combination of three forms: a) Pellicle: A mass of organisms is floating on top of the broth. b) Turbidity: The organisms appear as a general cloudiness throughout the broth. c) Sediment: A mass of organisms appears as a deposit at the bottom of the tube.
2) Slant tubes: are tubes containing a nutrient medium plus a solidifying agent, agar-agar. The medium has been allowed to solidify at an angle in order to get a flat inoculating surface. 3) Stab tubes (deeps): are tubes of hardened agar medium which are inoculated by "stabbing" the inoculum into the agar. 4) Agar plates: are sterile petri plates that are aseptically filled with a melted sterile agar medium and allowed to solidify. Plates are much less confining than slants and stabs and are commonly used in the culturing, separating, and counting of microorganisms.
Aseptic Technique v The most commonly used device for moving bacteria is the inoculating loop. v This is simply a piece of nichrome (an alloy of nickel and chromium) or platinum wire with a loop at one end a handle at the other. v A similar instrument is the inoculating needle, essentially the same as the loop, but with just a straight wire
v Sterilize both instruments by holding the wire portions in a flame until they glow red. The instruments should be allowed to cool in the air for 10 -20 seconds before using them to avoid killing the inoculum. v In this way all contaminants on the wire are incinerated. ü Do not blow on the instruments to cool them ü Do not touch the instruments to agar to cool them ü Do not lay the loop down once it is sterilized or it may again become contaminated.
Procedure For Aseptically Transfer 1) Flame the loop. 2) Without setting the loop down, open the first culture tube and flame the mouth. Do not set the cap on the bench. The cap should be held in the same hand as the loop. 3) Insert the loop into the culture medium, then withdraw it. 4) Flame the mouth of the first culture tube again, and replace the cap. 5) Open the second culture tube and flame the mouth. Do not set the cap on the bench. The cap should be held in the same hand as the loop.
6. Insert the loop into the second culture tube and spread the culture suspension (on the loop) inoculum into/onto the second culture medium. 7. Flame the mouth of the second culture tube, then replace the cap. 8. Flame the loop and set on the bench. 9. When in doubt about the sterility of an instrument or container, sterilize it.
Remember v. Bacteria § § § § § Are everywhere! On every surface of the body Including digestive tract Harmless Beneficial Pathogenic Absorb nutrients and release toxins that damage cells and tissues. Bacterial toxins can cause disease even when bacteria are destroyed Bacteria are Prokaryotes.
Five Basic Techniques of Culturing 1) 2) 3) 4) 5) Inoculate Incubate Isolation Examination Identification
Pure Culture Concept v Attempts to identify bacteria in a clinical sample cannot be done unless isolated colonies are used. v To obtain well-isolated colonies, it is essential to disperse the inoculum (sample) on the surface of an enriched agar plate so that individual bacteria are well separated from each other.
v Contaminants: other microorganisms present in the sample. v Isolated colonies: a population of millions of cells that are identical and are descendent from a single founder cell. v Stock Culture: a culture that already contains cells. It is used a source of cells from which to inoculate new cultures. v Culture Medium: rich/selective § § § Growth/ inhibitors liquid/solid temperature source of energy sources of carbon, nitrogen, . . . v Aseptic technique: § sterilization of medium and equipment § proper handling
Necessary equipment
Procedure 1) With the loop, spread the inoculum back and forth across the upper 1/4 of the plate, keeping the lines of inoculation very close together (area 1 in figure below). 2) Isolated colonies are not expected in this area. Do not use strong pressure, which will break the surface of the agar. Use the end of the loop, not its side when streaking. Dispose of the loop in the biohazard bucket on the bench. 3) Turn plate approximately 90 o. C. Streak the plate as indicated in the figure (area 2) across about 1/4 of the plate. Dispose of the loop.
4) Repeat step 2 one or two times more. 5) In area 3 and/or 4 single colonies should appear. 6) Label plates on the bottom and incubate inverted at 37 o. C. Note: Lids on test tubes are loose. Always hold the glass test tube (not the lid) when carrying them.
END OF LECTURE